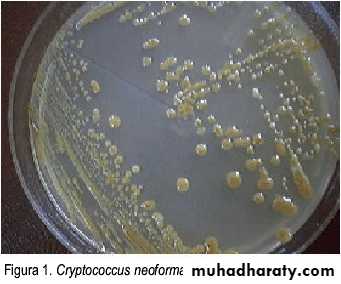
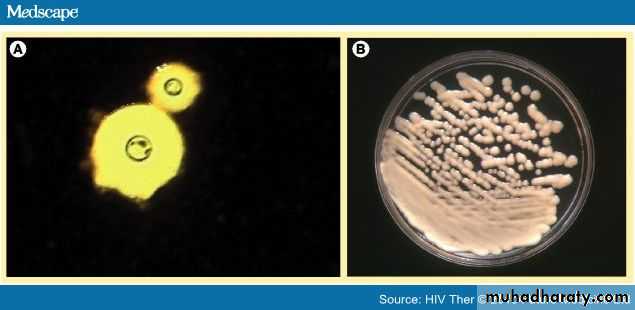

Cryptococcus
EpidemiologyCommon in immunocompromised patients ( AIDS )
An opportunistic fungal disease
There are about 50 species
Predominant pathogen is C.neofarmans
Other species such as C.albiodus and C.laurentii rarely cause disease in human
C. neoformans has 2 varieties ( neoformans and gattii )
Mycology
C.neoformans is found in temperate areas and found in pigeon droopingsC.gattii is found in tropics and not found in pigeon droopings
The two varieties are serotyped according to capsular polysaccharide
Four serotypes of C.neoformans ( A . B , C , D )
Serotype A is the most common
A&D serotypes are C.neoformans
B&C serotypes are C.gattii
Mycology
Growth of Cryptococcus takes 36 to 72 hours, and is slower than that of Candida and Saccharomyces species under the same conditions
White to creamcolored,smooth, mucoid colonies when grown on blood agar or Sabouraud dextrose agar
Transmitted by inhalation
C.neoformans grows at 37°C, whereas nonpathogenic species of Cryptococcus do not.
Produce melanin.
Life cycle
Pathogenicity
Polysaccharide capsuleThermotolerance
Melanin production
Manitol production
Soluble cextracellular onstituents
PathogenicityRole of capsule
Antiphagocytic
Poor stimulation of T-cells and cytokines
DiseasesPulmonary infection range (Asymptomatic to ARDS)
CNS infection (Meningitis)
Systemic infection
Skin infection
47-year-old man who underwent orthotopic heart transplantation one year ago has an x-ray showing a right upper lobe pulmonary nodule. The lung biopsy is shown. The most likely diagnosis is C.neoformans
47-year-old man who underwent orthotopic heart transplantation one year ago has an x-ray showing a right upper lobe pulmonary nodule. The lung biopsy is shown. The most likely diagnosis is C.neoformans
CNS infectionsCranial nerve manifestations
Decreased visual acuityBlindness
Diplopia
Hear loss
Facial weakness
Skin lesions
Diagnosis
Capsule India Ink stainAppear as a halo around the organism
Tissue biopsy stained by periodic
acid-Schiff
With the use of mucicarmine staining, the capsule look red
India ink stain of CSF
Gomori-methenaminesilver of biopsy
Culture
Sabouraud dextrose agar
White to creamcolored,smooth, mucoid colonies
DrugsAmphotericin B (severe infection)
Fluconazole